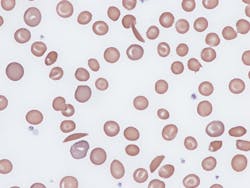
65bbbda26a824a001eeddd33 Dreamstime Xxl 280878453 1 65bbbda26a824a001eeddd33 Dreamstime Xxl 280878453 1

Administration announces action to increase access to sickle cell disease treatments
The Administration announced that sickle cell disease (SCD) will be the first focus of the Cell and Gene Therapy (CGT) Access Model, which was initially announced in February 2023. The model is designed to improve health outcomes, increase access to cell and gene therapies, and lower healthcare costs for some of the nation’s most vulnerable populations.
The model, led by the Centers for Medicare & Medicaid Services’ (CMS’) Innovation Center, will test outcomes-based agreements (OBAs) for groundbreaking CGTs. Successful OBAs will increase affordable access to potentially lifesaving and life-changing treatment. This model will begin in 2025 and may be expanded to other types of CGTs in the future.
Over the next year, CMS will partner with participating states and manufacturers to build a framework that expands access to gene therapies for the treatment of SCD. Under the model, CMS will negotiate an OBA with participating manufacturers, which will tie pricing for SCD treatments to whether the therapy improves health outcomes for people with Medicaid. Negotiations will also include additional pricing rebates and a standardized access policy. Participating states will then decide whether to enter into an agreement with manufacturers based on the negotiated terms and offer the agreed-upon standard access policy in exchange for rebates as negotiated by CMS. As part of the CGT Access Model, CMS will negotiate financial and clinical outcome measures with drug manufacturers and then reconcile data, monitor results, and evaluate outcomes. The CGT Access Model will begin in January 2025, and states may choose to begin participation at a time of their choosing between January 2025 and January 2026.
CMS anticipates addressing additional care delivery gaps and other hurdles for people receiving cell and gene therapy during the OBA negotiation process, including requiring manufacturers to include a defined scope of fertility preservation services when individuals receive gene therapy for treatment of SCD. CMS will also offer optional funding to states that engage in activities that increase equitable access to cell and gene therapies and promote multi-disciplinary, comprehensive care for people with Medicaid with SCD receiving gene therapy. These activities may include expanding or increasing reimbursement rates for optional Medicaid benefits and services, such as behavioral health or care management services.